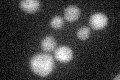
YBR153W
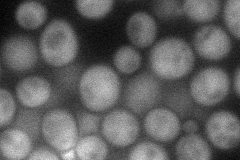
YBR153W
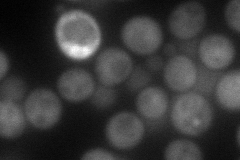
YBR153W
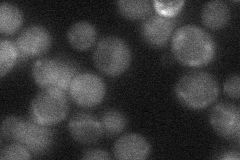
YBR153W
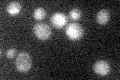
YBR153W

View description
Diaminohydroxyphoshoribosylaminopyrimidine deaminase; catalyzes the second step of the riboflavin biosynthesis pathway
Localization:
Intensity:
Fold change:
Significance:
-
C’ GFP library in SD
below threshold20.63 -
N' NOP1pr-GFP in SD
cytosol50.459 -
N' TEF2pr-mCherry in SD
cytosol76.5448 -
N' NATIVEpr-GFP in SD
cytosol25.9838 -
N' TEF2pr-VC and Cyto-VN in SD

#N/A0 -
C’ GFP library in SD+DTT

cytosol20.590.99No -
C’ GFP library in SD+H2O2

cytosol19.520.94No -
C’ GFP library in Starvation Media
cytosol20.841.01No -
C’ GFP library on the background of Pup2-DaMP

below threshold -
C’ GFP library on the background of CCT mutant

below threshold23.58851.14293No
